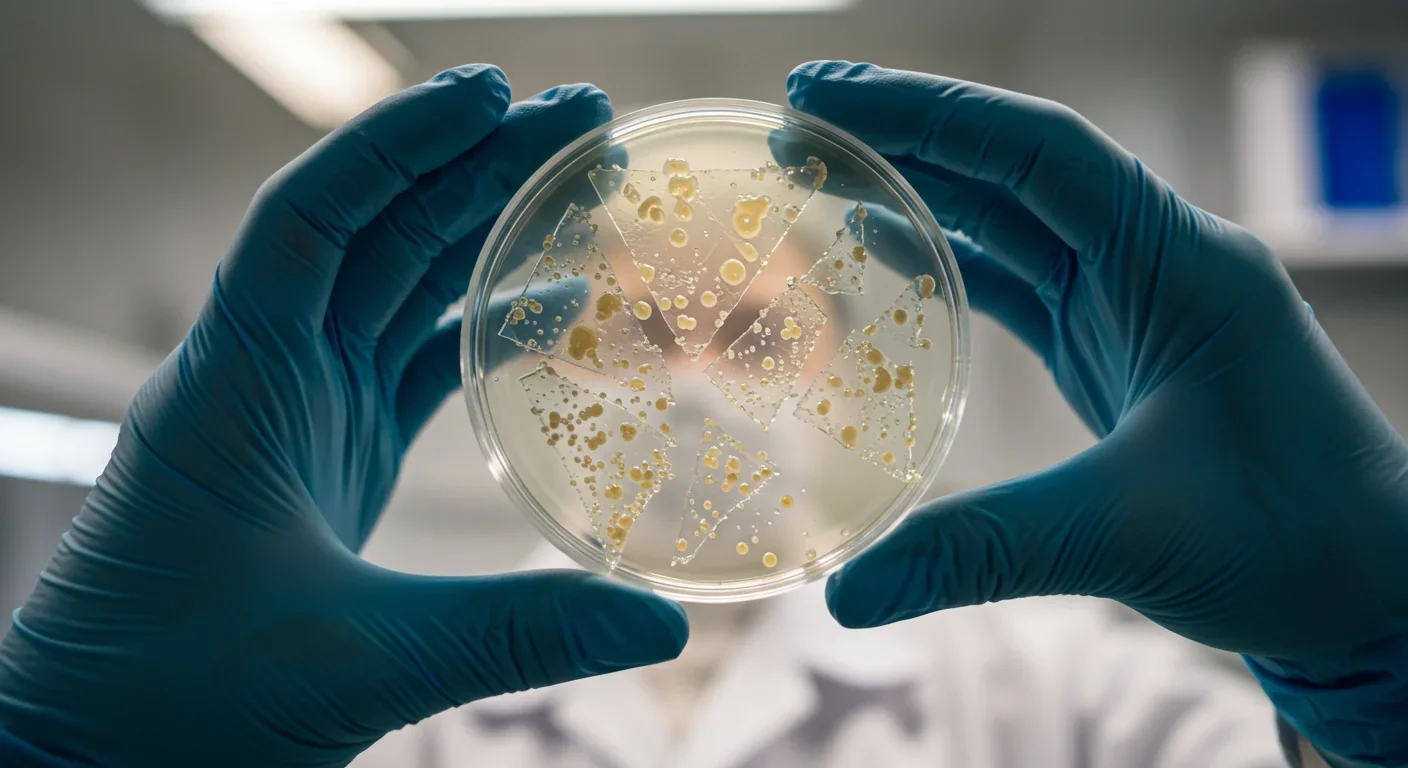
Bacterial colonies digesting PET plastic fragments in laboratory petri dish

Sharing Economy's Dirty Secret: More Sharing, More Waste

TL;DR: Scientists are engineering bacteria with plastic-eating enzymes that can break down PET in 24 hours, potentially transforming waste management and creating a circular plastic economy.

By 2050, researchers predict there will be more plastic in our oceans than fish by weight. But what if that nightmare scenario could be prevented by creatures so tiny they're invisible to the naked eye? Scientists are engineering bacteria with plastic-digesting enzymes that could fundamentally transform how humanity deals with its 400 million tons of annual plastic waste. This isn't science fiction anymore - it's happening in laboratories right now, and the implications could reshape everything from waste management to manufacturing.
The story begins in 2016, when Japanese scientists made an extraordinary find in a bottle recycling facility. They discovered Ideonella sakaiensis, a bacterium that naturally breaks down PET plastic - the material used in water bottles, food containers, and synthetic clothing. This microbe produces an enzyme called PETase that can actually digest plastic, something researchers thought impossible.
For decades, plastic seemed invincible. We designed it to last forever, and it succeeded spectacularly. A single plastic bottle can take 450 years to decompose naturally. But this tiny organism evolved an entirely new capability: it treats our most durable waste material as a snack. The discovery sent shockwaves through the scientific community because it proved that plastic biodegradation wasn't just theoretically possible - nature had already figured it out.
Scientists didn't stop at simply finding these bacteria. They've spent the past eight years engineering enhanced versions that work faster, tolerate higher temperatures, and handle a wider range of plastic types. The breakthrough came when researchers at the University of Texas used machine learning to redesign the enzyme at the molecular level.
The result is FAST-PETase, an engineered enzyme that breaks down plastic in as little as 24 hours - roughly 6,500 times faster than natural decomposition. Even more impressive, it works at temperatures below 50°C, meaning it doesn't require expensive heating infrastructure. The enzyme doesn't just destroy plastic; it completes a "circular process" by breaking it into molecular building blocks that can be reassembled into new, virgin-quality plastic.
Multiple research teams are taking different approaches. Some are focusing on increasing enzyme production in bacterial cells, while others engineer bacteria like Bacillus subtilis to secrete massive quantities of PETase into surrounding environments. Each strategy has distinct advantages: intracellular production protects enzymes from environmental stress, while secreted enzymes can act on plastics outside the cell.
The science behind plastic digestion is fascinating. PET plastic consists of long polymer chains made from repeating units of terephthalic acid and ethylene glycol. PETase enzymes act like molecular scissors, snipping these chains at specific points. They break the ester bonds holding the polymer together, gradually reducing massive plastic molecules into their original monomers.
But there's a critical second step. After PETase does its initial cutting, another enzyme called MHETase completes the job, converting intermediate products into pure terephthalic acid and ethylene glycol. These chemicals are the exact ingredients used to manufacture PET in the first place. It's the chemical equivalent of unscrambling an egg - something conventional recycling can't achieve.
This process differs fundamentally from mechanical recycling, which melts and reshapes plastic. Each time you mechanically recycle plastic, the polymer chains get shorter and the quality degrades. After a few cycles, the material becomes too degraded for most applications. Enzymatic recycling sidesteps this entirely by returning plastic to its molecular starting point, enabling true circular recycling without quality loss.
Laboratory success is one thing; deploying bacteria in actual landfills and wastewater systems is considerably more complex. The engineering challenges are immense. How do you keep bacteria alive in harsh environments? What prevents them from spreading uncontrollably into ecosystems? How do you collect the chemical byproducts they produce?
Researchers are exploring several deployment models. One approach involves contained bioreactors where shredded plastic gets mixed with bacteria cultures under controlled conditions. This is safer but requires infrastructure investment. Another strategy uses bacteria in wastewater treatment plants, where they could intercept microplastics before they reach rivers and oceans. Early trials show wastewater bacteria can break down common plastics without disrupting other treatment processes.
The most ambitious vision involves introducing engineered bacteria directly into landfills and contaminated environments. This raises immediate concerns about biosafety. What happens if plastic-eating bacteria mutate? Could they damage plastic infrastructure we actually need? These questions have real stakes - hospitals, for instance, rely on plastic medical devices. One study even found that Pseudomonas aeruginosa, a dangerous pathogen, can consume medical plastics, raising alarm about bacteria evolving to eat critical materials.
Releasing genetically modified organisms into the environment requires extensive regulatory approval. In the United States, engineered microorganisms face oversight from multiple agencies: the EPA regulates environmental release under TSCA and FIFRA, while the FDA oversees products intended for human use. The approval process can take years and requires comprehensive risk assessments.
Current regulations were designed for agricultural biotechnology, not environmental remediation. They focus on preventing gene flow to wild populations and assessing ecological impacts. But plastic-eating bacteria present novel challenges. Unlike crops confined to farms, environmental bacteria could potentially spread globally. Regulators must balance innovation against precaution.
International coordination adds another layer of complexity. Regulations vary dramatically between countries, from the EU's precautionary approach to more permissive frameworks in other regions. A bacterium released in one country doesn't respect borders. Developing global standards will be essential before widespread deployment becomes feasible.
The business case for enzymatic plastic recycling is becoming compelling. The global plastic waste management market is worth over $40 billion annually and growing. Companies that perfect this technology could capture enormous value while solving a crisis.
But the implications extend far beyond waste disposal. Manufacturing companies see an opportunity to transform plastic waste into valuable chemical feedstocks. Instead of mining petroleum for virgin plastic, factories could source materials from old bottles and packaging. This "urban mining" approach could reduce dependence on fossil fuels while creating new circular economy businesses.
Some researchers are even exploring how bacteria could convert plastic waste into higher-value products like pharmaceuticals. By engineering metabolic pathways, scientists can direct bacteria to transform plastic monomers into entirely different compounds. Imagine turning discarded water bottles into painkillers or industrial chemicals - it sounds absurd, but it's happening in laboratories today.
The cost dynamics are shifting rapidly. Traditional recycling often costs more than producing virgin plastic, which explains why only 9% of all plastic ever made has been recycled. Enzymatic processes could slash energy consumption by up to 65% compared to conventional recycling, potentially making recycled plastic cheaper than new plastic for the first time.
As with any transformative technology, the benefits may not distribute evenly. Wealthy nations with advanced biotechnology sectors could deploy these solutions quickly, while developing countries - often those most affected by plastic pollution - lack the infrastructure and expertise to implement them.
Consider the Global South, where informal waste picking provides livelihoods for millions of people. If automated biological systems replace human sorters, what happens to those workers? Technology-driven solutions risk recreating colonial patterns where innovations serve wealthy consumers while displacing vulnerable populations.
There's also a justice dimension to plastic pollution itself. Wealthy countries ship millions of tons of plastic waste to poorer nations annually. Even if we develop bacteria that can eat plastic, the burden of hosting waste processing facilities will likely fall on communities with the least political power to resist them.
Access to this technology will be determined by who controls the intellectual property. If patents concentrate in the hands of a few corporations, the benefits could remain exclusive. Open-source approaches to enzyme design and bacterial engineering could democratize access, but they face resistance from profit-seeking institutions that funded the research.
No technology exists without risks, and engineered bacteria present unique challenges. The primary concern is ecological: what happens if plastic-eating bacteria escape containment and spread into natural environments?
Some risks are obvious. If bacteria evolved to consume any plastic, they could damage infrastructure, from water pipes to vehicle components. The economic damage could be catastrophic. Less obvious is the potential for gene transfer to wild microbes, which could spread plastic-degrading capabilities unpredictably through bacterial populations.
There's also the problem of byproducts. When bacteria digest plastic, they release the chemical components into surrounding environments. Terephthalic acid and ethylene glycol are not benign - they're industrial chemicals with their own environmental impacts. Large-scale bacterial plastic digestion could introduce new forms of chemical pollution even as it solves the plastic problem.
Another concern is evolutionary pressure. As bacteria encounter diverse plastics in real environments, they'll evolve rapidly. We might inadvertently create super-degraders that consume materials we didn't intend, or they might lose their plastic-eating ability altogether as random mutations accumulate. Natural selection doesn't care about our engineering goals.

Different cultures and nations view biotechnology through distinct lenses. Japan, where the original plastic-eating bacterium was discovered, has embraced the research enthusiastically. The country sees it as aligned with traditional values of waste minimization and technological innovation.
European nations tend toward caution, with strong regulations on genetically modified organisms reflecting public skepticism about biotechnology. The EU's approach emphasizes the precautionary principle: don't deploy until you're certain of safety. This has slowed GMO adoption but arguably prevented some ecological mishaps.
In contrast, China has invested heavily in biotechnology research and development, including plastic-degrading organisms. The country produces the most plastic waste globally and faces severe pollution challenges, creating strong incentives to pursue aggressive solutions. Chinese researchers are exploring large-scale deployment scenarios that would be impossible in more regulated jurisdictions.
Developing nations face a different calculus entirely. Countries like Indonesia and the Philippines deal with overwhelming plastic pollution but lack resources for cutting-edge biotechnology. International collaboration could provide access to these technologies, but it requires technology transfer agreements and capacity building that often fail to materialize.
The transition from laboratory proof-of-concept to industrial-scale deployment will take years, possibly decades. Researchers identify several critical milestones that must be achieved.
First, enzyme production must scale dramatically. Current methods produce small quantities sufficient for experiments but nowhere near what industrial recycling would require. Increasing cytoplasmic expression and improving secretion pathways are active research areas. Scientists are engineering bacteria like E. coli and Bacillus subtilis to function as living factories, churning out enzymes by the ton.
Second, enzyme cocktails need optimization for real-world waste streams. Laboratory tests use clean, pure plastic. Actual waste is contaminated, mixed, and degraded. Enzymes must work on dirty plastic, tolerate other chemicals, and handle multiple plastic types simultaneously. Some research focuses on consortium approaches, using multiple bacterial species that work together to degrade complex waste mixtures.
Third, recovery systems must be developed to capture valuable monomers. It's not enough to break down plastic - you need to collect and purify the resulting chemicals for reuse. This requires integration with existing chemical processing infrastructure, which wasn't designed for biological inputs.
Within the next decade, you'll likely encounter plastic products made partly or entirely from enzymatically recycled materials. Some brands are already partnering with biotech firms to develop closed-loop systems where used products return to them for biological recycling.
Your community's waste management could change significantly. Instead of sorting plastic into numbered categories, you might simply separate "biologically recyclable" from everything else. Collection trucks could deliver plastic to biological processing facilities rather than traditional recycling centers or landfills.
The environmental calculations around plastic use will shift. Right now, even "recyclable" plastic mostly ends up in landfills because mechanical recycling is economically unfavorable. If enzymatic recycling becomes cost-effective, plastic could become genuinely circular. That might actually make some single-use applications more sustainable than alternatives like cotton bags, which require enormous resources to produce.
This technology might also influence product design. Manufacturers could optimize plastics for enzymatic digestion rather than durability alone. "Biodegradable by design" could become a selling point, with plastics engineered to break down efficiently in biological recycling facilities while remaining stable during normal use.
Despite tremendous progress, fundamental questions remain open. Can enzymes work fast enough to process the billions of tons of accumulated plastic waste? Will the economics ever favor biological recycling over producing virgin plastic from cheap petroleum? Can we prevent ecological risks while still deploying these organisms where they're needed most?
The technology also forces us to confront deeper questions about our relationship with waste. Do biological solutions address the root problem, or do they enable continued overconsumption by promising easy cleanup? There's a risk that plastic-eating bacteria become a technological band-aid that prevents more fundamental changes to production and consumption patterns.
The ethics of deploying genetically modified organisms at environmental scale remain contested. Who decides when the benefits outweigh the risks? Indigenous communities and environmental justice advocates rightly ask whether their consent matters when these decisions get made by distant scientists and policymakers.
Every civilization is defined partly by how it handles waste. Ancient Romans built sophisticated sewers. Medieval cities struggled with sanitation until plague forced innovation. The 20th century invented plastics that seemed magical - lightweight, durable, versatile - but we never solved the backend problem of what to do when we're done with them.
Plastic-eating bacteria represent a fundamentally new approach: instead of trying to destroy or contain problematic materials, we're recruiting biology to transform them. It's a philosophy that recognizes we can't engineer ourselves out of ecological problems with more industrial processes - sometimes the solution requires working with living systems.
This isn't just about plastic. The same principles could apply to other persistent pollutants: chemicals, pharmaceuticals, industrial compounds that accumulate in environments. We're learning to speak biology's language, to direct evolution toward solving problems of our own making. That's either our greatest hope or our most dangerous hubris.
The bacteria currently being engineered in laboratories might eventually work in landfills across the world, quietly transforming our most durable waste back into raw materials. Or they might remain confined to industrial facilities, processing plastic under carefully controlled conditions. Or regulatory fears and technical challenges might keep them locked in laboratories indefinitely.
What's certain is that we can no longer claim plastic pollution is unsolvable. The tools exist - we're simply deciding whether to use them, how to use them safely, and who benefits when we do. Those decisions will shape whether future generations inherit a planet drowning in plastic or one where our most problematic waste has become just another resource in a truly circular economy.

Saturn's moon Titan may harbour liquid water beneath its frozen crust, kept from freezing by ammonia acting as a natural antifreeze. New Cassini data suggests the interior could be slush with warm water pockets rather than a global ocean, and NASA's Dragonfly mission launching in 2028 aims to investigate whether this exotic environment could support life.

The cerebellum, long dismissed as merely a motor coordinator, forms dense circuits with the prefrontal cortex that shape cognition and emotion. Disruption of these pathways is now linked to schizophrenia, autism, and ADHD, opening new frontiers in diagnosis and non-invasive brain stimulation therapies.

Research shows the sharing economy often increases total resource consumption through the Jevons paradox and rebound effects. Ride-sharing adds billions of vehicle miles, co-working spaces use more energy per worker, and diffused responsibility erodes conservation behavior. Breaking the paradox requires congestion pricing, accountability design, and matching sharing models to appropriate resource types.

Illusory superiority causes most people to rate themselves above average in driving, intelligence, and ethics. This bias is rooted in metacognitive blind spots, shaped by culture, and carries real costs in healthcare, finance, and leadership. Structured feedback and institutional safeguards can help, but require ongoing effort.

Eastern skunk cabbage generates its own body heat through the alternative oxidase pathway, maintaining temperatures up to 35°C above freezing air and melting surrounding snow. This thermogenic ability, shared by roughly 90 plant species worldwide, reveals a level of metabolic sophistication that challenges assumptions about plant passivity.

America has 28 vacant homes for every homeless person, yet homelessness hit record highs in 2024. Speculative investment, geographic mismatches, and political barriers explain the paradox, while Finland and Vienna show that Housing First and social housing models can work when the political will exists.

Wafer-on-wafer bonding fuses logic and memory silicon at the atomic level, delivering up to 100x interconnect density over traditional packaging. TSMC, Intel, and Samsung are racing to commercialize the technology as AI chips hit the memory bandwidth wall.